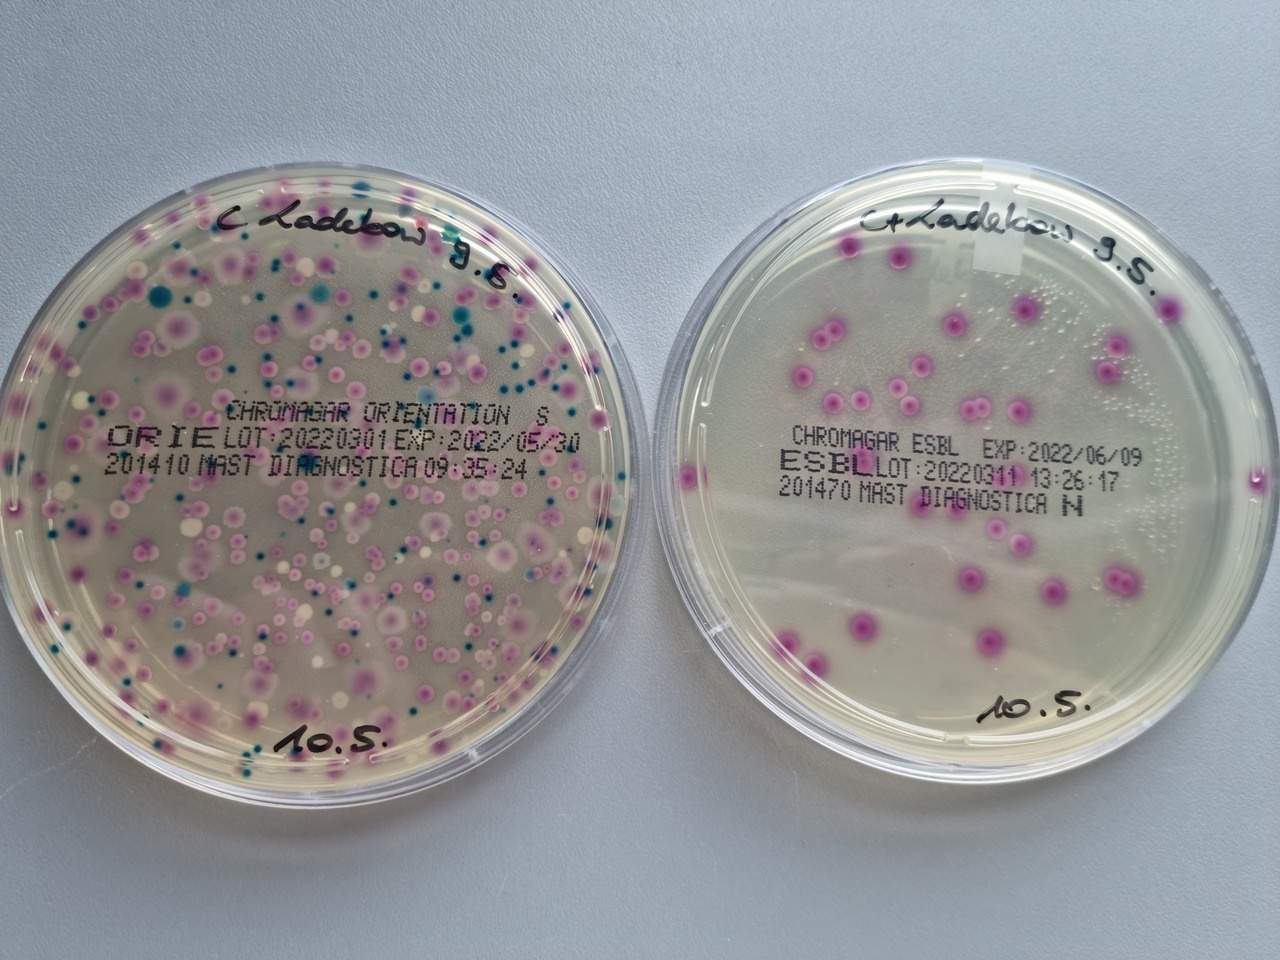
Multidrug-resistant high-risk clonal Escherichia coli lineages occur along an antibiotic residue gradient in the Baltic Sea

Multidrug-resistant high-risk clonal Escherichia coli lineages occur along an antibiotic residue gradient in the Baltic Sea
Published in Microbiology
Introduction to antimicrobial resistance
The World Health Organization defines antimicrobial resistance (AMR) as the gradual adaptation of microorganisms, making them resistant to treatments that once controlled them. This growing resistance limits therapeutic options, increasing the spread of diseases and leading to severe illness or death. Alarmingly, AMR bacteria are not confined to hospitals but are found worldwide—detected in humans, animals, and environments like soil and water. Water bodies are particularly concerning as they act as crossroads for the interaction of humans, animals, and ecosystems, accelerating the spread of resistant bacteria. Among the most troubling are species from the Enterobacterales order, such as Escherichia coli, a pathogen frequently linked to AMR-related deaths
The idea behind the paper
While there have been studies on the presence of multidrug-resistant (MDR) bacteria in certain water bodies, data on the Baltic Sea, which is significantly impacted by human activity, remains scarce. To address this gap, we investigated the surface water at various coastal locations near Greifswald (Germany) for the presence of MDR E. coli. Sampling took place over a year, from August 2021 to August 2022, and included three sites: (i) a recreational beach in Greifswald, (ii) an area close to the local wastewater treatment plant discharge, and (iii) a more rural spot on the island of Riems (Figure 1). Our goal was to analyze the isolated strains for phenotypic and genotypic traits, including resistance to antibiotics and heavy metals/metalloids that potentially co-select for AMR, virulence factors, and plasmids. Additionally, we quantified residues of five clinically used antibiotics to explore any potential link between antibiotic residue levels and the presence of resistant E. coli.
 Figure 1: Map of the sampling area close to Greifswald, Germany. The inset map of Germany indicates the geographical location of Greifswald. The sampling locations are indicated by alphabetic labels (A, B, and C) and different colors. The enclosed numerical values provide a quantification of the MDR E. coli strains isolated at the respective location. The map data was obtained from LUNG M-V and accessed on January 25, 2024.
Figure 1: Map of the sampling area close to Greifswald, Germany. The inset map of Germany indicates the geographical location of Greifswald. The sampling locations are indicated by alphabetic labels (A, B, and C) and different colors. The enclosed numerical values provide a quantification of the MDR E. coli strains isolated at the respective location. The map data was obtained from LUNG M-V and accessed on January 25, 2024.
Our results:
We isolated 30 resistant E. coli strains, some of which belong to international high-risk clonal lineages, including ST38, ST58, ST117, ST131, ST410, ST744, and ST1193 (Figure 2). Notably, we identified one strain resistant to cefiderocol, a drug approved by the FDA in 2019 for treating complicated urinary tract infections4. However, no resistance to carbapenems or colistin was detected. When testing tolerance to arsenic and mercury, we observed varying levels of resistance to heavy metals/metalloids. This is significant as resistance mechanisms like efflux pumps, which help bacteria expel toxic substances, can contribute to cross-resistance5.
 Figure 2: Mash distance analysis of the 30 ESBL-producing E. coli strains. Labels indicate the strain number and are colored according to their phylogroup as indicated in the legend. Annotations indicate (from inner to outer circle): sequence type (ST), sampling date, tolerance to arsenic and mercury, multidrug-resistant (MDR) phenotype, number of virulence-associated genes, and sampling spot. The extent of heavy metal tolerance is shown as circles, with no circles indicating low tolerance (arsenic, ≤8 µg/mL; mercury, ≤8 µg/mL), white circles indicating medium tolerance (arsenic, 256 µg/mL; mercury, 16 µg/mL), and black circles indicating high tolerance (arsenic, ≥512 µg/mL; mercury, ≥32 µg/mL).
Figure 2: Mash distance analysis of the 30 ESBL-producing E. coli strains. Labels indicate the strain number and are colored according to their phylogroup as indicated in the legend. Annotations indicate (from inner to outer circle): sequence type (ST), sampling date, tolerance to arsenic and mercury, multidrug-resistant (MDR) phenotype, number of virulence-associated genes, and sampling spot. The extent of heavy metal tolerance is shown as circles, with no circles indicating low tolerance (arsenic, ≤8 µg/mL; mercury, ≤8 µg/mL), white circles indicating medium tolerance (arsenic, 256 µg/mL; mercury, 16 µg/mL), and black circles indicating high tolerance (arsenic, ≥512 µg/mL; mercury, ≥32 µg/mL).
The strains carried a variety of genes linked to antibiotic resistance and virulence, including those involved in adherence, biofilm formation, and iron uptake. We also identified several plasmids, some of which contained antibiotic resistance genes, mercury resistance genes, or virulence-associated genes. Phenotypic tests revealed a wide range of biofilm formation abilities, from minimal to strong, while in vivo virulence testing in Galleria mellonella larvae demonstrated moderate to high mortality rates, highlighting the potential health risks posed by these strains.
Regarding the antibiotic residue analysis, the concentrations in the water samples were generally low, with a few exceptions. Notably, ciprofloxacin reached a concentration of 553 ng/L, which is relatively high compared to other water bodies. However, we found no clear link between antibiotic residue levels and the presence of specific antibiotic resistance genes in the AMR bacteria from the same water samples.
Conclusion
The presence of MDR bacteria with significant virulence traits and antibiotic residues in environmental waters poses a serious threat with unpredictable consequences, emphasizing the need for robust water quality monitoring and stricter regulations on discharges into marine environments. In the case of the Baltic Sea, which is shared by multiple countries, coordinated cross-border efforts are essential. Initial steps have been taken, such as by the Helsinki Commission (HELCOM)
References
1. Antimicrobial Resistance Collaborators. Global burden of bacterial antimicrobial resistance in 2019: a systematic analysis. The Lancet 399, 629–655; 10.1016/S0140-6736(21)02724-0 (2022).
2. Kocsis, B., Gulyás, D. & Szabó, D. Emergence and dissemination of extraintestinal pathogenic high-risk international clones of Escherichia coli. Life 12; 10.3390/life12122077 (2022).
3. Nappier, S. P., Liguori, K., Ichida, A. M., Stewart, J. R. & Jones, K. R. Antibiotic Resistance in Recreational Waters: State of the Science. Int J Environ Res Public Health 17; 10.3390/ijerph17218034 (2020).
4. Andrei, S., Droc, G. & Stefan, G. FDA approved antibacterial drugs: 2018-2019. Discoveries 7, e102; 10.15190/d.2019.15 (2019).
5. Mata, M. T., Baquero, F. & Pérez-Díaz, J. C. A multidrug efflux transporter in Listeria monocytogenes. FEMS Microbiol Lett 187, 185–188; 10.1111/j.1574-6968.2000.tb09158.x (2000).
6. UNESCO and HELCOM. Pharmaceuticals in the aquatic environment of the Baltic Sea region - A status report. UNESCO Emerging Pollutants in Water Series - No. 1 (2017).
Follow the Topic
-
npj Clean Water
This journal publishes high-quality papers which report cutting-edge science, technology, application, policy and societal issues that contribute towards a more sustainable supply of clean water.
Related Collections
With Collections, you can get published faster and increase your visibility.
Resource Recovery and Carbon Mitigation in Wastewater Treatment: Advancing the Water–Energy–Carbon Nexus
Publishing Model: Open Access
Deadline: Oct 31, 2026
Advanced Sensing and Data-Driven Approaches for Water Quality Monitoring
Publishing Model: Open Access
Deadline: Oct 31, 2026




Please sign in or register for FREE
If you are a registered user on Research Communities by Springer Nature, please sign in